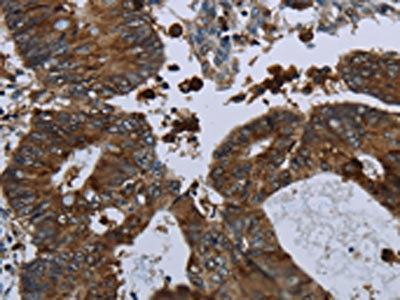

GLUL Antibody
-
中文名稱:GLUL兔多克隆抗體
-
貨號(hào):CSB-PA929928
-
規(guī)格:¥1100
-
圖片:
-
The image on the left is immunohistochemistry of paraffin-embedded Human liver cancer tissue using CSB-PA929928(GLUL Antibody) at dilution 1/60, on the right is treated with fusion protein. (Original magnification: ×200)
-
The image on the left is immunohistochemistry of paraffin-embedded Human colon cancer tissue using CSB-PA929928(GLUL Antibody) at dilution 1/60, on the right is treated with fusion protein. (Original magnification: ×200)
-
Gel: 8%SDS-PAGE, Lysate: 40 μg, Lane 1-2: Mouse liver tissue, Mouse brain tissue, Primary antibody: CSB-PA929928(GLUL Antibody) at dilution 1/650, Secondary antibody: Goat anti rabbit IgG at 1/8000 dilution, Exposure time: 10 seconds
-
-
其他:
產(chǎn)品詳情
-
Uniprot No.:
-
基因名:
-
別名:cell proliferation-inducing protein 59 antibody; Cgl2214 antibody; GLNA antibody; GLNA_HUMAN antibody; GLNS antibody; GLUL antibody; Glutamate ammonia ligase antibody; Glutamate decarboxylase antibody; Glutamate--ammonia ligase antibody; glutamine synthase antibody; Glutamine synthetase antibody; glutamine synthetase I antibody; GS antibody; PIG 43 antibody; PIG 59 antibody; PIG43 antibody; PIG59 antibody; Proliferation inducing protein 43 antibody
-
宿主:Rabbit
-
反應(yīng)種屬:Human,Mouse,Rat
-
免疫原:Fusion protein of Human GLUL
-
免疫原種屬:Homo sapiens (Human)
-
標(biāo)記方式:Non-conjugated
-
抗體亞型:IgG
-
純化方式:Antigen affinity purification
-
濃度:It differs from different batches. Please contact us to confirm it.
-
保存緩沖液:-20°C, pH7.4 PBS, 0.05% NaN3, 40% Glycerol
-
產(chǎn)品提供形式:Liquid
-
應(yīng)用范圍:ELISA,WB,IHC
-
推薦稀釋比:
Application Recommended Dilution ELISA 1:2000-1:5000 WB 1:500-1:2000 IHC 1:100-1:300 -
Protocols:
-
儲(chǔ)存條件:Upon receipt, store at -20°C or -80°C. Avoid repeated freeze.
-
貨期:Basically, we can dispatch the products out in 1-3 working days after receiving your orders. Delivery time maybe differs from different purchasing way or location, please kindly consult your local distributors for specific delivery time.
-
用途:For Research Use Only. Not for use in diagnostic or therapeutic procedures.
相關(guān)產(chǎn)品
靶點(diǎn)詳情
-
功能:Glutamine synthetase that catalyzes the ATP-dependent conversion of glutamate and ammonia to glutamine. Its role depends on tissue localization: in the brain, it regulates the levels of toxic ammonia and converts neurotoxic glutamate to harmless glutamine, whereas in the liver, it is one of the enzymes responsible for the removal of ammonia. Essential for proliferation of fetal skin fibroblasts. Independently of its glutamine synthetase activity, required for endothelial cell migration during vascular development: acts by regulating membrane localization and activation of the GTPase RHOJ, possibly by promoting RHOJ palmitoylation. May act as a palmitoyltransferase for RHOJ: able to autopalmitoylate and then transfer the palmitoyl group to RHOJ. Plays a role in ribosomal 40S subunit biogenesis.
-
基因功能參考文獻(xiàn):
- findings reveal that, in addition to the known formation of glutamine, the enzyme glutamine synthetase shows unknown activity in endothelial cell migration during pathological angiogenesis through RHOJ palmitoylation PMID: 30158707
- In silico analysis potentially links GLUL SNPs with major depression disorder. PMID: 29441491
- The SNP rs10911021 near glutamate-ammonia ligase is associated with oxidative stress in coronary heart disease patients from Pakistan. PMID: 29304826
- ASCT2 was significantly overexpressed in the gastric cancer (GC) samples compared with adjacent non-cancerous gastric mucosa, in contrast, a significantly higher level of glutamine synthetase (GS) expression was observed in normal tissues than in GC samples compared with adjacent non-cancerous gastric mucosa. PMID: 29435734
- The data identify GS activity as mediator of the proangiogenic, immunosuppressive, and pro-metastatic function of M2-like macrophages and highlight the possibility of targeting this enzyme in the treatment of cancer metastasis. PMID: 28813676
- Data show that 1,25-dihydroxyvitamin D (1,25D) downregulation of glutamine synthetase (GLUL; GS)) was sufficient to reduce abundance and enzyme activity of GS. PMID: 29029014
- genome-wide association study to identify genetic factors for familial hepatitis B virus-related hepatocellular carcinoma; results identified 2 large effect susceptible haplotypes located at GLUL and SLC13A2/FOXN1 PMID: 28662289
- GLUL knockdown markedly inhibited the p38 MAPK and ERK1/ERK2 signaling pathways in cultured breast cancer cells and reduces their proliferation. PMID: 27791265
- co-targeting glutamine synthetase in stroma and glutaminase in cancer cells reduces tumor weight, nodules, and metastasis. PMID: 27829138
- This study demonstrated that Influence of glutamine synthetase gene polymorphisms on the development of hyperammonemia during valproic acid-based therapy. PMID: 26599579
- GS is acetylated at lysines 11 and 14, yielding a degron that is necessary and sufficient for binding and ubiquitylation by CRL4(CRBN) and degradation by the proteasome. PMID: 26990986
- Studied molecular mechanisms of glutamine synthetase mutations that lead to clinically relevant pathologies. PMID: 26836257
- GLUL rs10911021 is associated prospectively with adjudicated cardiovascular composite end points among overweight/obese individuals with type 2 diabetes. PMID: 26395743
- Data show that glutamine synthetase (GS) produces glutamine (Gln) from tricarboxylic acid (TCA)-cycle-derived carbons. PMID: 26595383
- findings point to SNP rs10911021 of GLULas an independent modulator of mortality in patients with type 2 diabetes PMID: 25677913
- Results highlight the diagnostic errors that can be caused by variant patterns of staining with glutamine synthetase and serum amyloid-associated protein in inflammatory hepatocellular adenoma and focal nodular hyperplasia. PMID: 23807780
- High Glutamine synthetase expression is associated with epilepsy in newly diagnosed glioblastoma multiforme. PMID: 23410662
- Glutamine synthetase expression is increased in regenerating hepatocytes and in early hepatocyte progenitor cells prior to morphological evidence of hepatocellular differentiation. PMID: 23362937
- through a 3-stage genome-wide association study in 4188 type 2 diabetic patients, identified a novel susceptibility locus for coronary heart disease in the region of the GLUL gene PMID: 23982368
- these results suggest that GLUL contributes to pancreatic regeneration. PMID: 22930410
- The presence of GS in the post-acrosomal region of the perinuclear theca suggests that human sperm can carry out in glutamine synthesis. PMID: 22777743
- Data show that the acidification followed by neutralisation (AFBN) pre-treatment protocol for cerebrospinal fluid (CSF) significantly enhances the measurement of glutamine synthetase (GS) and myelin basic protein (MBP) in CSF. PMID: 22542401
- This study suggests that serum glutamine synthetase levels have no diagnostic value for Alzheimer's disease. PMID: 21597934
- glutamine synthetase expression can be used to distinguish astrocytic from oligodendroglial tumors and may play a role in the pathogenesis of astrocytomas. PMID: 21682567
- The Glul can serve as novel target in diabetes mellitus genetic therapy. PMID: 20536387
- Glutamine synthetase was up-regulated in hepatocellular carcinoma and may be a novel marker for early diagnosis. PMID: 20525558
- Standard histology and glutamine synthase status identify a hepatocellular carcinoma subset with distinct clinical and pathologic features. PMID: 20233882
- 2D fingerprinting & mass spectrometry reveal specific targets of protein oxidation in Alzheimer's disease brain, including glutamine synthase, suggesting involvement of oxidatively modified proteins in neurodegeneration. PMID: 12160938
- The detection of a significantly reduced enzymatic activity in the epileptic amygdala supports the assumption that the enzyme defect is localized to the epileptic mesial temporal lobe of corresponding patients. PMID: 16095760
- Liver tissue samples from HCV-HCC cancerous tissues and corresponding non-cancerous tissues from patients showed three protein spots of the same molecular mass (42 kDa), whose expression increased in well-differentiated cancerous tissues. PMID: 16609938
- In myocytes and hepatomas, but not in adipocytes, glutamine acts to moderate glutamine synthetase induction by glucocorticoids. PMID: 17197094
- We confirmed the induction of GS expression by dexamethasone published previously. Components of the glutamatergic system may play a role in bone pathophysiology PMID: 17627080
- Crystal structure of GLUL illustrates substrate-induced conformational change and provides opportunities for drug and herbicide design. PMID: 18005987
- in solid pseudopapillary neoplasm of the pancreas glutamine synthetase expression is highly correlated with Wnt/beta-catenin activation, demonstrating its faithfulness as a Wnt target gene PMID: 18192886
- glutamine synthetase has a role in control of glutamate signalling through Wnt3A and steroid pathways in osteoblastic cells PMID: 18555765
- Glutamine synthetase can be found during early human fetal stages when it displays a significant effect on cell proliferation PMID: 18662667
- This study suggests that seizures in GBM are coupled with a highly localized glutamine synthetase deficiency. PMID: 19183851
- GS localization was investigated using immunohistochemistry and double-labeling of young and adult human and rat skin sections as well as skin cells in culture. PMID: 19204801
- GS mRNA and protein expression was not different between normal and fetal growth restriction pregnancy PMID: 19500843
顯示更多
收起更多
-
相關(guān)疾?。?/div>Congenital systemic glutamine deficiency (CSGD)亞細(xì)胞定位:Cytoplasm, cytosol. Microsome. Mitochondrion. Cell membrane; Lipid-anchor.蛋白家族:Glutamine synthetase family組織特異性:Expressed in endothelial cells.數(shù)據(jù)庫鏈接:
Most popular with customers
-
YWHAB Recombinant Monoclonal Antibody
Applications: ELISA, WB, IHC, IF, FC
Species Reactivity: Human, Mouse, Rat
-
-
-
-
-
-
-